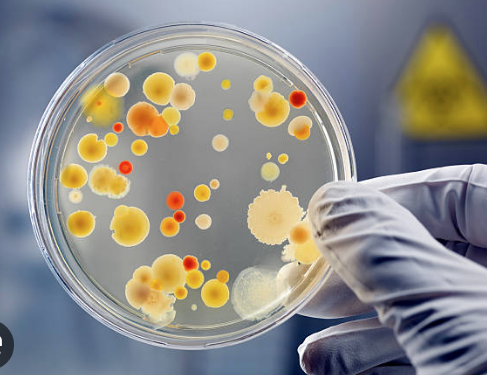
GMO’dan donmuş gıdalarla ilgili uyarı

Gıda Mühendisleri Odası (GMO), çözündürülen donmuş gıdaların, tekrardan dondurulmaması ve çözündürmenin buzlukta yapılması uyarısında bulundu.
Gıda Mühendisleri Odası’ndan donmuş gıdalarla ilgili yapılan uyarıda, donmuş gıdaları çözündürürken yanlış uygulamaların gıda zehirlenmesine neden olabileceği belirtildi.
Dondurma aşamasında mikroorganizma üremesinin durduğu, ancak çözündürürken mikroorganizma üremesinin tekrardan, hızla başladığı belirtilen açıklamada, “Çözündürülmüş olan bir gıda kesinlikle tekrar dondurulmamalıdır. Aksi halde içerisinde mikroorganizmalar üreyecek ve bir sonraki tüketiminde besin zehirlenmelerine sebebiyet verebilecektir.” denildi.
-Buzdolabında çözündürün
Donmuş gıdaların buzdolabında çözündürmenin en güvenli yöntem olduğu, buzdolabı gıdaların 4°C’nin altında tutulmasını sağladığından bakterilerin çoğalmasını engellediği kaydedilen açıklamada, çözdürülecek olan gıdanın buzdolabında bekletilirken bir kap içerisine tutulması gerektiğini aksi halde besinden damlayacak mikroorganizmalı sular başka bir besine bulaşarak çapraz kontaminasyona sebebiyet olabileceği kaydedildi.
Mikrodalga fırında da çözündürmenin güvenli bir yöntem olduğu kaydedilen açıklamanın bazı dondurulmuş gıdaların, etiket talimatlarına uyularak, doğrudan pişirilmesinin de güvenli olduğu ifade edildi.
-Oda sıcaklığında çözündürülmemeli
Oda sıcaklığında çözündürmenin, bakterilerin hızla çoğalmasına ve gıdanın bozulmasına neden olabileceği de kaydedildi.
Sıcak Su Kullanımının da gıdaların dış yüzeyinin hızla ısınmasına ve bakterilerin
çoğalmasına neden olabileceği belirtildi.